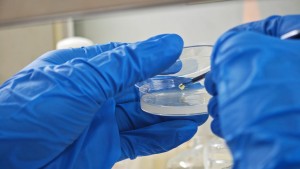
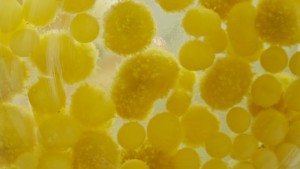

网上摄影网站群
第六届全国青年摄影大展入展作品——特别主题:青年生活方式类
 来源:中国摄影家协会网
来源:中国摄影家协会网
 责编:Lee.W
责编:Lee.W
 2025-06-16
2025-06-16
陈畅《90后社交运动——腰旗橄榄球》组照01
陈畅《90后社交运动——腰旗橄榄球》组照02
陈畅《90后社交运动——腰旗橄榄球》组照03
陈畅《90后社交运动——腰旗橄榄球》组照04
陈畅《90后社交运动——腰旗橄榄球》组照05
陈畅《90后社交运动——腰旗橄榄球》组照06
陈畅《90后社交运动——腰旗橄榄球》组照07
陈畅《90后社交运动——腰旗橄榄球》组照08
陈畅《90后社交运动——腰旗橄榄球》组照09
陈畅《90后社交运动——腰旗橄榄球》组照10
陈泳伟《山中打卡的时尚青年》组照01
陈泳伟《山中打卡的时尚青年》组照02
陈泳伟《山中打卡的时尚青年》组照03
陈泳伟《山中打卡的时尚青年》组照04
陈泳伟《山中打卡的时尚青年》组照05
陈泳伟《山中打卡的时尚青年》组照06
陈泳伟《山中打卡的时尚青年》组照07
陈泳伟《山中打卡的时尚青年》组照08
郭庆萍《“95”后小伙儿的飞机梦》组照01
郭庆萍《“95”后小伙儿的飞机梦》组照02
郭庆萍《“95”后小伙儿的飞机梦》组照03
郭庆萍《“95”后小伙儿的飞机梦》组照04
郭庆萍《“95”后小伙儿的飞机梦》组照05
郭庆萍《“95”后小伙儿的飞机梦》组照06
郭庆萍《“95”后小伙儿的飞机梦》组照07
郭庆萍《“95”后小伙儿的飞机梦》组照08
何涛《勒多曼因》组照01
何涛《勒多曼因》组照02
何涛《勒多曼因》组照03
何涛《勒多曼因》组照04
何涛《勒多曼因》组照05
何涛《勒多曼因》组照06
何涛《勒多曼因》组照07
何涛《勒多曼因》组照08
何涛《勒多曼因》组照09
何涛《勒多曼因》组照10
何涛《勒多曼因》组照11
何涛《勒多曼因》组照12
李翀《自媒体年代》组照01
李翀《自媒体年代》组照02
李翀《自媒体年代》组照03
李翀《自媒体年代》组照04
李翀《自媒体年代》组照05
李翀《自媒体年代》组照06
李翀《自媒体年代》组照07
李翀《自媒体年代》组照08
李翀《自媒体年代》组照09
李翀《自媒体年代》组照10
李向雨《62名硕士博士扎根汶川放飞梦想》组照01
李向雨《62名硕士博士扎根汶川放飞梦想》组照02
李向雨《62名硕士博士扎根汶川放飞梦想》组照03
李向雨《62名硕士博士扎根汶川放飞梦想》组照04
李向雨《62名硕士博士扎根汶川放飞梦想》组照05
李向雨《62名硕士博士扎根汶川放飞梦想》组照06
李向雨《62名硕士博士扎根汶川放飞梦想》组照07
李向雨《62名硕士博士扎根汶川放飞梦想》组照08
李向雨《62名硕士博士扎根汶川放飞梦想》组照09
李向雨《62名硕士博士扎根汶川放飞梦想》组照10
李向雨《62名硕士博士扎根汶川放飞梦想》组照11
李向雨《62名硕士博士扎根汶川放飞梦想》组照12
李向雨《62名硕士博士扎根汶川放飞梦想》组照13
李向雨《62名硕士博士扎根汶川放飞梦想》组照14
李向雨《62名硕士博士扎根汶川放飞梦想》组照15
李向雨《62名硕士博士扎根汶川放飞梦想》组照16
邱夏子《英歌记忆》组照01
邱夏子《英歌记忆》组照02
邱夏子《英歌记忆》组照03
邱夏子《英歌记忆》组照04
邱夏子《英歌记忆》组照05
邱夏子《英歌记忆》组照06
邱夏子《英歌记忆》组照07
王登峰《青春日常-想象的假装成为现实景观》组照01
王登峰《青春日常-想象的假装成为现实景观》组照02
王登峰《青春日常-想象的假装成为现实景观》组照03
王登峰《青春日常-想象的假装成为现实景观》组照04
王登峰《青春日常-想象的假装成为现实景观》组照05
王登峰《青春日常-想象的假装成为现实景观》组照06
王登峰《青春日常-想象的假装成为现实景观》组照07
王登峰《青春日常-想象的假装成为现实景观》组照08
王登峰《青春日常-想象的假装成为现实景观》组照09
王登峰《青春日常-想象的假装成为现实景观》组照10
王登峰《青春日常-想象的假装成为现实景观》组照11
王登峰《青春日常-想象的假装成为现实景观》组照12
谢雨潼《捷克海洋》组照01
谢雨潼《捷克海洋》组照02
谢雨潼《捷克海洋》组照03
谢雨潼《捷克海洋》组照04
谢雨潼《捷克海洋》组照05
谢雨潼《捷克海洋》组照06
谢雨潼《捷克海洋》组照07
于宽《倾城》组照01
于宽《倾城》组照02
于宽《倾城》组照03
于宽《倾城》组照04
于宽《倾城》组照05
于宽《倾城》组照06
赵迪《开车摆摊的年轻人》组照01
赵迪《开车摆摊的年轻人》组照02
赵迪《开车摆摊的年轻人》组照03
赵迪《开车摆摊的年轻人》组照04
赵迪《开车摆摊的年轻人》组照05
赵迪《开车摆摊的年轻人》组照06
赵迪《开车摆摊的年轻人》组照07
赵迪《开车摆摊的年轻人》组照08
周杨《废墟中的光影》组照01
周杨《废墟中的光影》组照02
周杨《废墟中的光影》组照03
周杨《废墟中的光影》组照04
周杨《废墟中的光影》组照05
周勇《生物多样性调查——影像与科研深度融合》组照01
周勇《生物多样性调查——影像与科研深度融合》组照02
周勇《生物多样性调查——影像与科研深度融合》组照03
周勇《生物多样性调查——影像与科研深度融合》组照04
周勇《生物多样性调查——影像与科研深度融合》组照05
周勇《生物多样性调查——影像与科研深度融合》组照06
周勇《生物多样性调查——影像与科研深度融合》组照07
周勇《生物多样性调查——影像与科研深度融合》组照08
周勇《生物多样性调查——影像与科研深度融合》组照09
周勇《生物多样性调查——影像与科研深度融合》组照10
周勇《生物多样性调查——影像与科研深度融合》组照11
周勇《生物多样性调查——影像与科研深度融合》组照12
周勇《生物多样性调查——影像与科研深度融合》组照13
周勇《生物多样性调查——影像与科研深度融合》组照14
周勇《生物多样性调查——影像与科研深度融合》组照15
周勇《生物多样性调查——影像与科研深度融合》组照16
周勇《生物多样性调查——影像与科研深度融合》组照17
周勇《生物多样性调查——影像与科研深度融合》组照18
周勇《生物多样性调查——影像与科研深度融合》组照19
周勇《生物多样性调查——影像与科研深度融合》组照20
陈楚红《奥运冠军风采》
倪政东《“神将”也爱马拉松》
苏晓杰《刀山敢上、火海敢闯》
孙向博《大学寝室里的光》
田思慧《水下走钢丝》
王先源《恰同学少年》